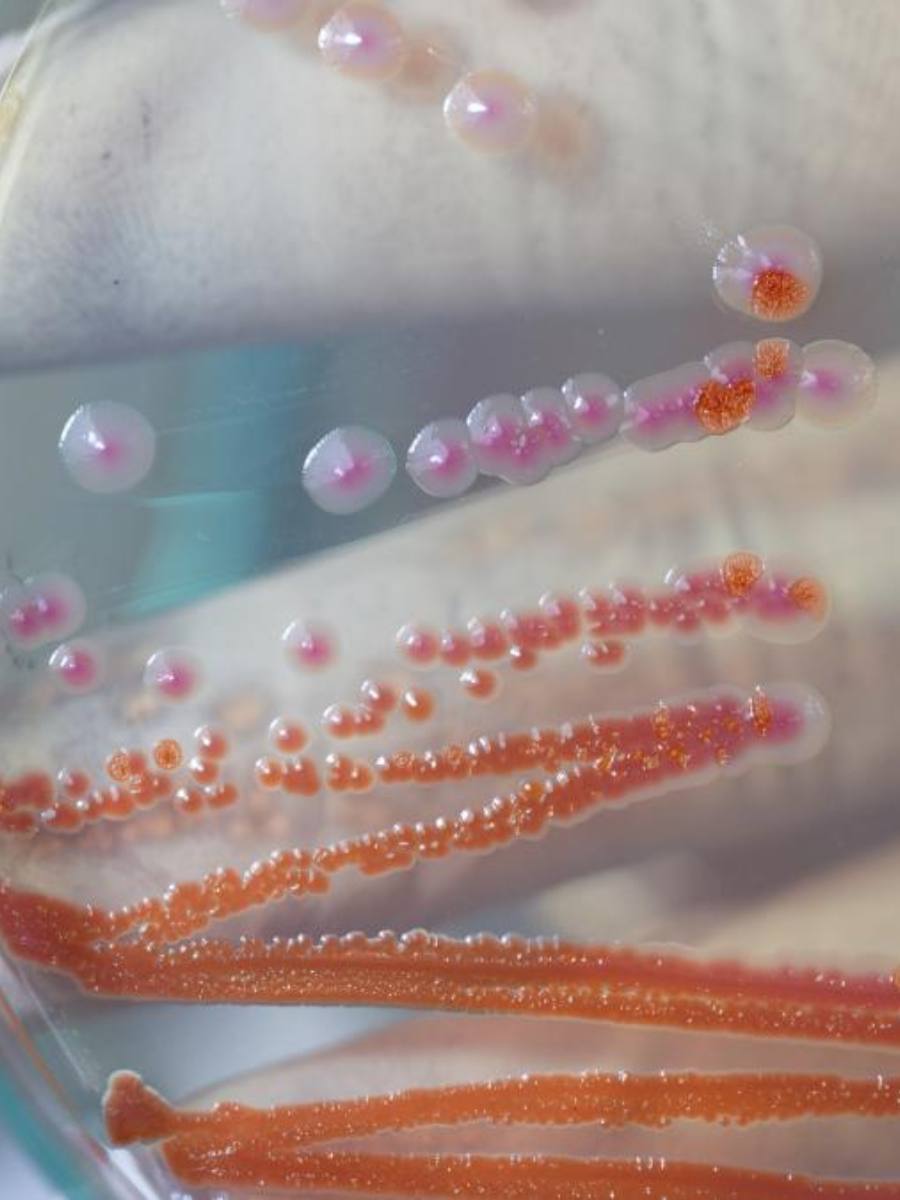

Copii uciși de o bacterie periculoasă într-un spital din România: Șase copii internați la secția de Terapie Intensivă a Spitalului de Copii „Sfânta Maria” din Iași au murit după ce au fost infectați cu bacteria Serratia Marcescens, un germen cu evoluție extrem de agresivă. Direcția de Sănătate Publică Iași a deschis o anchetă epidemiologică pentru a stabili dacă unitatea medicală a luat măsurile necesare la timp.
Copii uciși de o bacterie periculoasă într-un spital din România: primele cazuri și semnele de alarmă
Potrivit reprezentanților spitalului, primul caz a fost înregistrat pe 7 septembrie, iar în jurul datei de 16 au apărut și alte cazuri, ceea ce a ridicat suspiciunea unui focar. Conducerea unității susține că a anunțat Direcția de Sănătate Publică pe 15 septembrie, însă ministrul Sănătății, Alexandru Rogobete, afirmă că raportarea oficială a fost făcută abia pe 19, ceea ce a întârziat intervenția autorităților.
Ministrul acuză spitalul că nu a informat DSP conform legii și nu a acționat suficient de rapid pentru limitarea răspândirii infecției. În consecință, Ministerul Sănătății a anunțat aplicarea primelor sancțiuni, iar inspectorii DSP verifică dacă procedurile de igienă și control epidemiologic au fost respectate.
Citiți și ► Apă contaminată! Decese la granița cu Germania, regiunea raportează cel mai mare focar din istorie
Ce este bacteria Serratia Marcescens
Bacteria identificată este un agent patogen care se dezvoltă mai ales în medii umede și poate cauza infecții severe la pacienții imunodeprimați. În cazul copiilor internați la ATI, majoritatea cu afecțiuni grave, evoluția a fost rapidă și fatală. Specialiștii avertizează că acest germen poate provoca pneumonii, infecții urinare sau chiar sepsis, fiind extrem de dificil de controlat în secțiile cu pacienți vulnerabili.
Medicii din spital susțin că au luat măsuri de urgență: au limitat internările, au intensificat igienizarea, au testat soluțiile sterile, produsele de sânge și aparatura medicală. Totodată, personalul medical a fost reinstruit pentru respectarea protocoalelor de igienă.
Ancheta epidemiologică și multe controverse
Diferențele dintre datele raportate de spital și cele comunicate de Ministerul Sănătății ridică semne de întrebare asupra transparenței și reacției instituțiilor. În prezent, ancheta DSP urmărește să stabilească dacă focarul putea fi izolat mai devreme și dacă există posibile surse interne de contaminare.
Din cei nouă copii internați în momentul apariției focarului, șase au decedat, unul a fost transferat la București, unul se află pe secția de oncologie, iar un singur copil rămâne internat la ATI. În prezent, nu se mai fac internări în corpul afectat al secției.
Ironia tragică este că Spitalul de Copii „Sfânta Maria” din Iași a fost complet renovat recent, lucrările fiind finalizate în 2023 cu o investiție de aproape 139 de milioane de lei prin fonduri europene.